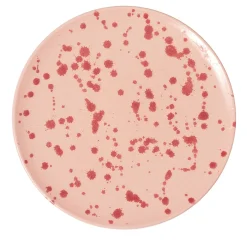
Rose and Burgundy Ceramic Decorative Plate

Candle in 100% soy wax and cotton wick combined with a ceramic lid handmade by qualified Italian craftsmen based on an exclusive design by the designer Carola Altamura. The color of the ceramic is matched with the fragrance of lavender and iris, thus creating a unique product. The candle is hand-poured by a historic Italian candle factory with respect for nature and tradition. An aromatic fragrance with a timeless charm that combines the flowery notes of lavender with fougere notes of the iris.
MaterialCeramicsDimensions (in)W 3.1 x D 3.1 x H 4.7Product referenceCAROBD-044Tearsheet

Reviews
There are no reviews yet.